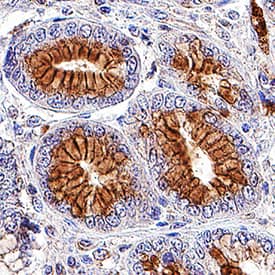
Axl antibody in Human Stomach by Immunohistochemistry (IHC-P).

Human Axl Antibody
R&D Systems, part of Bio-Techne | Catalog # AF154


Key Product Details
Validated by
Species Reactivity
Validated:
Cited:
Applications
Validated:
Cited:
Label
Antibody Source
Product Specifications
Immunogen
Glu33-Pro440
Accession # AAA61243
Specificity
Clonality
Host
Isotype
Scientific Data Images for Human Axl Antibody
Detection of Human Axl by Western Blot.
Western blot shows lysates of HeLa human cervical epithelial carcinoma cell line. PVDF membrane was probed with 1.0 µg/mL of Goat Anti-Human Axl Antigen Affinity-purified Polyclonal Antibody (Catalog # AF154) followed by HRP-conjugated Anti-Goat IgG Secondary Antibody (HAF017). A specific band was detected for Axl as an approximately 140 kDa glycoprotein (as indicated). This experiment was conducted using Immunoblot Buffer Group 2.Detection of Axl in A431 Human Cell Line by Flow Cytometry.
A431 human epithelial carcinoma cell line was stained with Goat Anti-Human Axl Affinity-Purified Polyclonal Antibody (Catalog # AF154, filled histogram) or normal goat IgG control antibody (AB-108-C, open histogram) followed by APC-conjugated anti-Goat IgG Secondary Antibody (F0108). View our protocol for Staining Membrane-associated Proteins.Axl in Human Stomach.
Axl was detected in immersion fixed paraffin-embedded sections of human stomach using Goat Anti-Human Axl Antigen Affinity-purified Polyclonal Antibody (Catalog # AF154) at 3 µg/mL for 1 hour at room temperature followed by incubation with the Anti-Goat IgG VisUCyte™ HRP Polymer Antibody (VC004). Tissue was stained using DAB (brown) and counterstained with hematoxylin (blue). Specific staining was localized to plasma membranes of epithelial cells in gastric glands. View our protocol for IHC Staining with VisUCyte HRP Polymer Detection Reagents.Applications for Human Axl Antibody
Blockade of Receptor-ligand Interaction
CyTOF-ready
Flow Cytometry
Sample: K562 human chronic myelogenous leukemia cell line, HeLa human cervical epithelial carcinoma cell line, or A431 human epithelial carcinoma cell line
Immunohistochemistry
Sample: Immersion fixed paraffin-embedded sections of human stomach
Knockout Validated
Simple Western
Sample: HUVEC human umbilical vein endothelial cells.
Western Blot
Sample: HeLa human cervical epithelial carcinoma cell line
Reviewed Applications
Read 7 reviews rated 4.3 using AF154 in the following applications:
Formulation, Preparation, and Storage
Purification
Reconstitution
Formulation
Shipping
Stability & Storage
- 12 months from date of receipt, -20 to -70 °C as supplied.
- 1 month, 2 to 8 °C under sterile conditions after reconstitution.
- 6 months, -20 to -70 °C under sterile conditions after reconstitution.
Background: Axl
Axl (Ufo, Ark), Dtk (Sky, Tyro3, Rse, Brt), and Mer (human and mouse homologues of chicken c-Eyk) constitute a subfamily of the receptor tyrosine kinases (1, 2). The extracellular domains of these proteins contain two Ig-like motifs and two fibronectin type III motifs. This characteristic topology is also found in neural cell adhesion molecules and in receptor tyrosine phosphatases. The human Axl cDNA encodes an 887 amino acid (aa) precursor that includes an 18 aa signal sequence, a 426 aa extracellular domain, a 21 aa transmembrane segment, and a 422 aa cytoplasmic domain. The extracellular domains of human and mouse Axl share 81% aa sequence identity. A short alternately spliced form of human Axl is distinguished by a 9 aa deletion in the extracellular juxtamembrane region. These receptors bind the vitamin K-dependent protein growth arrest specific gene 6 (Gas6) which is structurally related to the anticoagulation factor protein S. Binding of Gas6 induces receptor autophosphorylation and downstream signaling pathways that can lead to cell proliferation, migration, or the prevention of apoptosis (3). This family of tyrosine kinase receptors is involved in hematopoiesis, embryonic development, tumorigenesis, and regulation of testicular functions.
References
- Yanagita, M. (2004) Curr. Opin. Nephrol. Hypertens. 13:465.
- Nagata, K. et al. (1996) J. Biol. Chem. 22:30022.
- Holland, S. et al. (2005) Canc. Res. 65:9294.
Long Name
Alternate Names
Gene Symbol
UniProt
Additional Axl Products
Product Documents for Human Axl Antibody
Product Specific Notices for Human Axl Antibody
For research use only